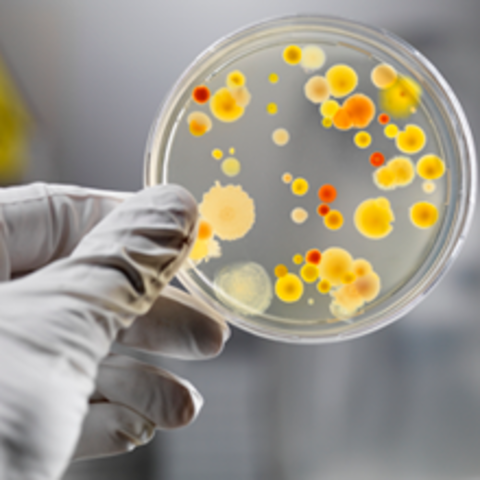
Microbial Genome Project

-
An expressed sequence tag is a short-sub sequence of cDNA sequence. All expressed sequence tags duplicate sequences from genes. Expressed sequence tags were first proposed as a good way to find genes in the genome in 1991. 1/10 of the human genome is thought to be expressed.
-
The DOE and NIH set up a way to share resources and ideas a way that they agreed upon during this time. Them together can complete many, many things.
-
The second generation map of the human genome is a micro-satellite genetic map of the whole human genome. The first genetic map spanned the entire human genome and was used with genetic markers. The second was built by a team in France.Human genome maps help scientists to discover diseases quicker.
-
The National Institutes of Health and the Department of Energy made a ton of progress working to establish a new set of goals two years ahead of what they had it scheduled to be. The plan had on it, encouraging technology research, better ways of sequencing, and new goals for created detailed genetic and physical maps
-
FLAVR SAVR Tomato are tomatoes that can be left on the vine longer before shipping. This was the first genetically modified food. These were sold from 1994-1999
-
One of the goals of the Human Genome Project's five-year plan was to complete a detailed genetic map of the human genome by 1995. Genetic mapping was used for the hunt for disease genes. The idea behind a genetic map is that if a particular genetic marker is inherited with a disease gene, the gene likely resides near the genetic marker.
-
The DOE began a MGP in late 1994 this was done so that you the genomes of some bacteria could be sequenced. The microbes the DOE chose do not cause disease but are important for their environmental, energy, and roles.
-
The purpose is to provide equal opportunity for individuals with disabilities Equal Employment stated that the ADA would protect individuals subjected to discrimination on the "genetic information relating to illness or disorders". The guidance stated that a person with a genetic test showing a predisposition for cancer would be protected under the ADA based on the predisposition if employer regards a person as having a disability and discriminates against him or her because of that perception.
Want to make a timeline like this?
Use Timetoast to turn dates, events, milestones, and phases into a clear visual timeline you can build and share. Timetoast is a timeline maker for work, school, research, and stories.